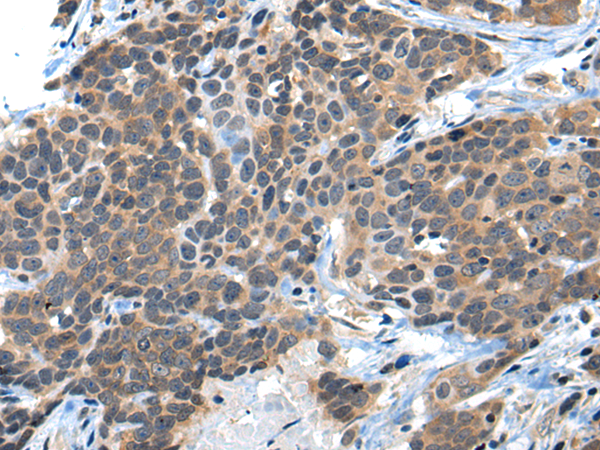

中文名稱:兔抗CKS2多克隆抗體
|
Background: |
CKS2 protein binds to the catalytic subunit of the cyclin dependent kinases and is essential for their biological function. The CKS2 mRNA is found to be expressed in different patterns through the cell cycle in HeLa cells, which reflects specialized role for the encoded protein. |
|
Applications: |
ELISA, IHC |
|
Name of antibody: |
CKS2 |
|
Immunogen: |
Synthetic peptide of human CKS2 |
|
Full name: |
CDC28 protein kinase regulatory subunit 2 |
|
Synonyms: |
CKSHS2 |
|
SwissProt: |
P33552 |
|
ELISA Recommended dilution: |
5000-10000 |
|
IHC positive control: |
Human thyroid cancer |
|
IHC Recommend dilution: |
25-100 |
購(gòu)物車
購(gòu)物車 幫助
幫助
 021-54845833/15800441009
021-54845833/15800441009
